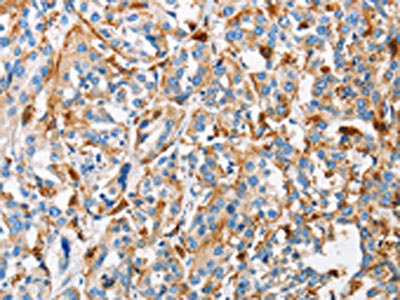

CTSL Antibody
-
中文名稱:CTSL兔多克隆抗體
-
貨號:CSB-PA996311
-
規格:¥1100
-
圖片:
-
The image on the left is immunohistochemistry of paraffin-embedded Human esophagus cancer tissue using CSB-PA996311(CTSL Antibody) at dilution 1/50, on the right is treated with fusion protein. (Original magnification: ×200)
-
The image on the left is immunohistochemistry of paraffin-embedded Human thyroid cancer tissue using CSB-PA996311(CTSL Antibody) at dilution 1/50, on the right is treated with fusion protein. (Original magnification: ×200)
-
-
其他:
產品詳情
-
Uniprot No.:
-
基因名:
-
別名:Cathepsin L antibody; cathepsin L; 1 b antibody; Cathepsin L1 antibody; Cathepsin L1 light chain antibody; CathepsinL antibody; CATL antibody; CATL1_HUMAN antibody; cb15 antibody; CTSL antibody; CTSL1 antibody; ctsl1b antibody; FLJ31037 antibody; hgg1 antibody; Major excreted protein antibody; MEP antibody; MGC123162 antibody; wu:fb30g09 antibody
-
宿主:Rabbit
-
反應種屬:Human
-
免疫原:Fusion protein of Human CTSL
-
免疫原種屬:Homo sapiens (Human)
-
標記方式:Non-conjugated
-
抗體亞型:IgG
-
純化方式:Antigen affinity purification
-
濃度:It differs from different batches. Please contact us to confirm it.
-
保存緩沖液:-20°C, pH7.4 PBS, 0.05% NaN3, 40% Glycerol
-
產品提供形式:Liquid
-
應用范圍:ELISA,IHC
-
推薦稀釋比:
Application Recommended Dilution ELISA 1:2000-1:5000 IHC 1:50-1:200 -
Protocols:
-
儲存條件:Upon receipt, store at -20°C or -80°C. Avoid repeated freeze.
-
貨期:Basically, we can dispatch the products out in 1-3 working days after receiving your orders. Delivery time maybe differs from different purchasing way or location, please kindly consult your local distributors for specific delivery time.
-
用途:For Research Use Only. Not for use in diagnostic or therapeutic procedures.
相關產品
靶點詳情
-
功能:Thiol protease important for the overall degradation of proteins in lysosomes (Probable). Plays a critical for normal cellular functions such as general protein turnover, antigen processing and bone remodeling. Involved in the solubilization of cross-linked TG/thyroglobulin and in the subsequent release of thyroid hormone thyroxine (T4) by limited proteolysis of TG/thyroglobulin in the thyroid follicle lumen. In neuroendocrine chromaffin cells secretory vesicles, catalyzes the prohormone proenkephalin processing to the active enkephalin peptide neurotransmitter. In thymus, regulates CD4(+) T cell positive selection by generating the major histocompatibility complex class II (MHCII) bound peptide ligands presented by cortical thymic epithelial cells. Also mediates invariant chain processing in cortical thymic epithelial cells. Major elastin-degrading enzyme at neutral pH. Accumulates as a mature and active enzyme in the extracellular space of antigen presenting cells (APCs) to regulate degradation of the extracellular matrix in the course of inflammation. Secreted form generates endostatin from COL18A1. Critical for cardiac morphology and function. Plays an important role in hair follicle morphogenesis and cycling, as well as epidermal differentiation. Required for maximal stimulation of steroidogenesis by TIMP1.; Functions in the regulation of cell cycle progression through proteolytic processing of the CUX1 transcription factor. Translation initiation at downstream start sites allows the synthesis of isoforms that are devoid of a signal peptide and localize to the nucleus where they cleave the CUX1 transcription factor and modify its DNA binding properties.; (Microbial infection) In cells lacking TMPRSS2 expression, facilitates human coronaviruses SARS-CoV and SARS-CoV-2 infections via a slow acid-activated route with the proteolysis of coronavirus spike (S) glycoproteins in lysosome for entry into host cell. Proteolysis within lysosomes is sufficient to activate membrane fusion by coronaviruses SARS-CoV and EMC (HCoV-EMC) S as well as Zaire ebolavirus glycoproteins.
-
基因功能參考文獻:
- the findings demonstrated that mutated K-ras promotes cathepsin L expression and plays a pivotal role in EMT of human lung cancer. The regulatory effect of IR-induced cathepsin L on lung cancer invasion and migration was partially attributed to the Cathepsin L /CUX1-mediated EMT signaling pathway PMID: 29246726
- Cathepsin L (CTSL) has been shown to participate in the microglia-mediated neuroinflammation.Level of CTSL was positively correlated with expression of inflammatory mediators and NF-kappaB in Parkinson's disease patients. PMID: 29154036
- The key findings of this study provided evidence suggesting that miR-152 functions by means of binding to CTSL to induce GIST cell apoptosis and inhibit proliferation, migration, and invasion. PMID: 29278883
- identify Cat L as a key intracellular lysosomal gene encoding progranulin protease PMID: 28743268
- these data suggest that oxidative stress prevents the protective autophagy by inhibition of CTSL processing PMID: 28478025
- The active CATL activity and the expression of the mature single-chain enzyme are lowest the umbilical cord arteries and highest in Wharton's jelly. PMID: 28787468
- these findings suggest that CTSL functions as a carcinogenic factor and may contribute to Paclitaxel resistance in human ovarian cancer PMID: 27351223
- An association between higher serum cathepsin L and increased risk of cardiovascular mortality was found in two independent cohorts. Impaired kidney function appears to be an important moderator or mediator of these associations. PMID: 27718373
- CTSL is an important protein which mediates cell invasion and migration of human glioma U251 cells. PMID: 27989700
- Collectively, these data indicate that CTSL is an important contributor to tumor angiogenesis and that the CTSL inhibition may have therapeutic utility in the treatment of breast cancer patients. PMID: 27055649
- Therefore, we show for the first time that the nuclear localization of Cat L and its substrate Cux1can be positively regulated by Snail NLS and importin beta1, suggesting that Snail, Cat L and Cux1 all utilize importin beta1 for nuclear import. PMID: 28698143
- Data suggest substrate specificity of CTSL includes SNCA; CTSL truncates SNCA first at C-terminus before attacking internal beta-sheet-rich region between residues 30 and 100; three of four proteolysis sites contain glycine residues likely involved in beta-turn, where proteolysis leads to solvent exposure of internal residues and further proteolysis of amyloid. (CTSL = cathepsin L; SNCA = alpha-synuclein) PMID: 28614652
- Cathepsin L knockdown induced by RNA interference significantly promoted curcumin-induced cytotoxicity, apoptosis, and cell cycle arrest. The knockdown also inhibited the migration and invasion of glioma cells. Cathepsin L may be a new target to enhance the efficacy of curcumin against cancers. PMID: 27373979
- a positive feedback loop between Snail-nuclear Cat L-CUX1 drives epithelial mesenchymal transition, is reprted. PMID: 27956696
- Kidney tubule/glomerulus cathepsin L expression did not change in cyclosporine A-treated nephrotic syndrome. PMID: 26975192
- the crystal structure determined at 1.4 A revealed that the cathepsin L molecule is cleaved, with the cleaved region trapped in the active site cleft of the neighboring molecule. PMID: 26992470
- endothelial CTSL up-regulation partially due to Fli1 deficiency may contribute to the development of vasculopathy, while the decrease in dermal CTSL expression is likely associated with dermal fibrosis in systemic sclerosis PMID: 26661692
- CTSL may contribute to gefitinib resistance in non-small-cell lung cancer PMID: 26474873
- The study results indicate the A-allele of rs3118869 [of the human cathepsin Lgene] is a protective factor in hypertension. PMID: 26374357
- Data suggest that nuclear cathepsin L accelerates cell cycle progression of HCT116 colorectal carcinoma cells. PMID: 26343556
- Mechanistic studies showed that teicoplanin blocks Ebola virus entry by specifically inhibiting the activity of cathepsin L, opening a novel avenue for the development of additional glycopeptides as potential inhibitors of cathepsin L-dependent viruses. PMID: 26953343
- Cathepsin L targeting in cancer treatment PMID: 26299995
- cathepsin L activity was decreased in p53 positive cells after adriamycin treatment, but not in p53 negative cells. PMID: 26757339
- these data indicate that the CTSL inhibitor KGP94 has the potential to alleviate metastatic disease progression and associated skeletal morbidities and hence may have utility in the treatment of advanced prostate cancer patients PMID: 26757413
- Our findings highlight the potential role of CTSL in the cross talk between autophagy and apoptosis, which might be considered a therapeutic strategy for treatment of pathologic conditions associated with neurodegeneration. PMID: 26797274
- Knockdown of Cathepsin L promotes radiosensitivity of glioma stem cells both in vivo and in vitro. PMID: 26706414
- In addition, cathepsin L positively correlates with MMP2. PRACTICE: The cathepsin L may be used as a monitoring index in age-related diseases. PMID: 25991043
- TGFbetainduced epithelialmesenchymal transition was associated with increased cathepsin L in A549 and MCF7 cells. CATL may be involved in the regulation of EMT. CATL knockdown in A549 cells inhibited xenograft tumor growth and EMT in vivo PMID: 25632968
- study showed plasma cathepsin L may be used as an independent predictor of prognosis in pancreatic cancer; this protease may be one of the factors responsible for tumor invasion, as its level was found to be significantly higher in pancreatic tumor tissues compared to non-neoplastic adjacent tissue PMID: 25516668
- in vivo functional evidence for overexpressed CTSL as a promoter of lung metastasis, whereas high CTSL levels are maintained during tumor progression due to stress-resistant mRNA translation. PMID: 25957406
- CTSL might involve in the development and progression of HCC as a oncogene. PMID: 25384089
- the results suggested that CTSL contributes to the proliferation and metastasis of OC, and that CTSL may be a novel molecular target for OC treatment. PMID: 25333746
- Overexpression of CTSL is involved in tumor invasion and metastasis in ovarian cancer. PMID: 24402045
- CTSL protein level was positively associated with forced expiratory volume in emphysema. The C allele of rs2274611 was associated with increased protein level. CTSL may be involved in the development of airflow limitation. PMID: 23900981
- The increase in cathepsins B and L activities in lymphosarcoma tissues is caused by cyclophosphamide induction of apoptosis. PMID: 24319737
- correlation of plasma CatL levels with aortic diameter and the lowest ankle-brachial index suggest that this cysteinyl protease plays a detrimental role in the pathogenesis of peripheral arterial diseases and abdominal aortic aneurysms PMID: 23958260
- Data suggest that CTSL (cathepsin L) and CTSB (cathepsin B) of the autophagic-lysosomal proteolytic system are involved as the main proteolytic system in skeletal muscle during cancer cachexia development in patients with esophageal cancer. PMID: 24108784
- Oxidized low-density lipoprotein upregulated CATL protein levels and activation in human umbilical vein endothelial cells (ECs) in a concentration-dependent manner and stimulated EC autophagy and apoptosis and increased EC monolayer permeability. PMID: 23229094
- Both cathepsin L and matrix metalloprotease-2 showed correlation with some of the clinicopathological parameters in pancreatic cancer but only cathepsin L expression in tumor epithelium predicted a poor prognosis for the disease. PMID: 23915070
- TMPRSS2 and HAT activate HCoV-229E for cathepsin L-independent virus-cell fusion. PMID: 23536651
- Cathepsin L expression is related to the invasive and metastatic potential of oral squamous cell carcinoma. PMID: 22963824
- BRCA1 loss activates cathepsin L (CTSL)-mediated degradation of 53BP1. PMID: 23337117
- In this study, various molecular dynamics (MD) simulations of pro- and mature human cathepsins L and O were performed. PMID: 23009386
- conclude that common genetic variation in the proximal CTSL1 promoter, especially at position C-171A, is functional in cells, and alters transcription so as to explain the association of CTSL1 with BP in vivo PMID: 22871890
- Cathepsin L has a significant impact on antigen-induced arthritis severity by influencing the selection of Th cell populations in the thymus, but seems not play any significant role in the direct joint destruction PMID: 22674323
- DHA supplementation significantly suppressed the expression of low-density lipoprotein receptor and cathepsin L1, both of which were also up-regulated by LPS. PMID: 21775114
- Cathepsins L and Z are critical in degrading polyglutamine-containing proteins within lysosomes. PMID: 22451661
- Regulation of cathepsins S and L by cystatin F during maturation of dendritic cells. PMID: 22365146
- Report transient expression of progesterone receptor and cathepsin-l in human granulosa cells during the periovulatory period. PMID: 22281037
- high-resolution structures reveal that the backbone C=O group of Gly61 in most cathepsin L co-crystal structures maintains water solvation while engaging in halogen bonding PMID: 21898833
顯示更多
收起更多
-
亞細胞定位:Lysosome. Apical cell membrane; Peripheral membrane protein; Extracellular side. Cytoplasmic vesicle, secretory vesicle, chromaffin granule. Secreted, extracellular space. Secreted.; [Isoform 2]: Nucleus.
-
蛋白家族:Peptidase C1 family
-
數據庫鏈接:
Most popular with customers
-
-
YWHAB Recombinant Monoclonal Antibody
Applications: ELISA, WB, IHC, IF, FC
Species Reactivity: Human, Mouse, Rat
-
Phospho-YAP1 (S127) Recombinant Monoclonal Antibody
Applications: ELISA, WB, IHC
Species Reactivity: Human
-
-
-
-
-